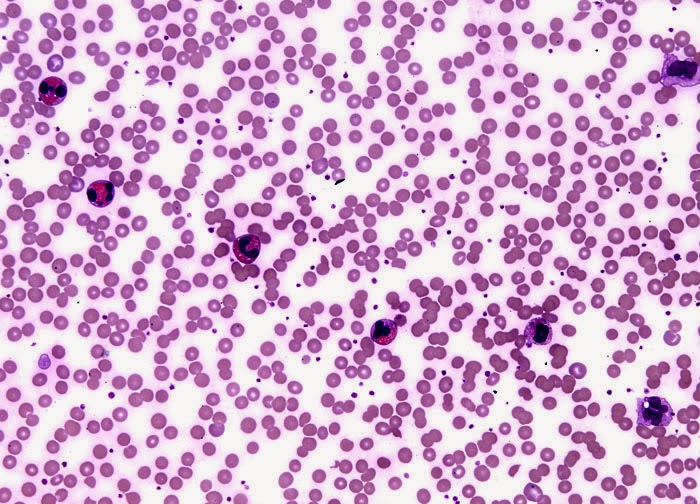

Eosinophilia
The term Eosinophilia refers to conditions in which abnormally high amounts of Eosinophils are found in either the blood or in body tissues.
Eosinophil is a type of white blood cell.
Eosinophils are produced in the bone marrow and are normally found in the bloodstream and the gut lining. They contain proteins that help the body to fight infection from parasitic organisms, such as worms. But in certain diseases these proteins can damage the body.
Causes for Eosinophilia
The exact causative mechanisms of Eosinophilia remain largely unclear
A wide range of conditions, ranging from asthma and hay fever to parasitic infections, autoimmune diseases,
Certain forms of cancer have been known to trigger an abnormally high amount of Eosinophils.
Very common Causes of Eosinophilia
- Asthma
- Eczema
- Sarcoptes scabiei
- Scabies
 Common Causes of Eosinophilia
Common Causes of Eosinophilia
- Connective tissue disease
- Food allergy
- Psoriasis
- Systemic lupus erythematosus
Symptoms
- Skin allergy
- Cough
- Frequent cold attack
- Throat irritation
- Bone pain or tenderness
- Carpal tunnel syndrome
- Joint contractures
- Muscle weakness
- Tenderness and swelling of the arms and legs (occasionally including joints)
- Thickened skin with puckered appearance
Homeopathy Treatment for Eosinophilia
Symptomatic Homeopathic medicines stimulate the immune power to resist against the disease. So Symptomatic homeopathic medicines works well in Eosinophilia.
Whom to contact for Eosinophilia Treatment
Vivekanantha Clinic Doctors treats many cases of High Eosinophilis, Increased Esinophils, Allergy, with successful results. Many patients get relief after taking treatment from Vivekanantha Clinic. You can meet the Doctors at Vivekanantha Homeopathy Clinic, Velachery, Chennai 42. To get appointment please call 9786901830, +91 94430 54168 or mail to consult.ur.dr@gmail.com,
For more details & Consultation Feel free to contact us.
Vivekanantha Clinic Consultation Champers
at
Chennai:- 9786901830
Pondicherry:- 9865212055
Panruti:- 9443054168
For appointment please Call us or Mail Us
==–==
Feel Free to Contact us
esnopelia treatment in chennai, eznopelia treatment in chennai, esnophils treatment, isnophil isnophelia treatment in chennai, high eosinophilia treatment in tamil, increased esinophil in blood treatment, ஈஸ்னோபீலியா சிகிச்சை தமிழில், ஈசினேபிலியா சிகிச்சை, ரத்தத்தில் இசுனோபில் அதிகம், இசுனோபிலியா சிகிச்சை,